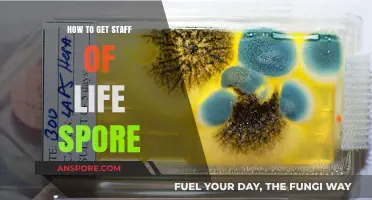
Mastering the Art of Obtaining Staff of Life Spores

Obtaining spores is a fundamental step for anyone interested in cultivating mushrooms, whether for culinary, medicinal, or scientific purposes. Spores, the reproductive units of fungi, can be sourced through various methods, including collecting them from mature mushroom caps, purchasing spore syringes or prints from reputable suppliers, or even isolating them from natural environments like decaying wood or soil. Each method requires careful attention to sterility and proper technique to ensure the spores remain viable for cultivation. Understanding the legal and ethical considerations surrounding spore collection is also crucial, as regulations vary by region. With the right approach, acquiring spores opens the door to the fascinating world of mycology and mushroom cultivation.
| Characteristics | Values |
|---|---|
| Source | Spores can be obtained from various sources including wild mushrooms, spore prints, spore syringes, and spore swabs. |
| Wild Mushrooms | Collect mature mushrooms with open caps, place them gill-side down on paper or glass to capture falling spores. |
| Spore Prints | A direct imprint of spores from a mushroom's gills, typically made by placing the cap on a surface for several hours. |
| Spore Syringes | Sterile syringes containing spore solution, often used for inoculation in mushroom cultivation. |
| Spore Swabs | Sterile swabs dipped in spore solution, used for transferring spores to a substrate. |
| Online Vendors | Spores can be purchased from reputable online vendors, ensuring legality and quality. |
| Legality | Spores themselves are legal in many regions, but their use for cultivation may be regulated. Check local laws. |
| Storage | Spores can be stored in a cool, dark place for several months to years, depending on the storage method. |
| Viability | Freshly collected spores have higher viability, ensuring successful germination. |
| Sterility | Sterile techniques are crucial when handling spores to prevent contamination. |
| Cultivation | Spores are used to inoculate a substrate, which is then maintained under controlled conditions for mushroom growth. |
| Species | Different mushroom species have unique spore characteristics, affecting cultivation methods and outcomes. |
| Microscopy | Spores can be viewed under a microscope for identification and study. |
| DIY Kits | Some vendors offer DIY spore collection kits for beginners. |
| Community | Joining mycology communities can provide guidance and resources for spore collection and cultivation. |
What You'll Learn
- Wild Harvesting: Locate mature mushrooms, gently collect spores using a blade or brush, store in paper envelopes
- Spore Prints: Place mushroom cap gills-down on paper, cover, let spores drop, scrape and store
- Online Vendors: Purchase spore syringes or prints from reputable suppliers, ensure legality in your region
- Sterile Lab Techniques: Use agar plates, sterile tools, and pressure cookers to isolate and cultivate spores
- Spore Swabs: Swab mushroom gills with a sterile cotton swab, transfer spores to a storage medium

Wild Harvesting: Locate mature mushrooms, gently collect spores using a blade or brush, store in paper envelopes
Mature mushrooms are nature’s spore factories, and wild harvesting allows you to tap into this natural process. Look for mushrooms with fully opened caps and gills exposed, as these are prime for spore release. Species like *Coprinus comatus* (shaggy mane) or *Psathyrella candolleana* (grave waxcap) are excellent candidates due to their prolific spore production. Timing is critical—collect when the mushroom is neither too young nor too decayed, typically 2–3 days after the cap fully opens. A magnifying lens can help you assess gill maturity and ensure optimal spore viability.
To collect spores, precision is key. Use a sterile scalpel or fine brush to gently dislodge spores from the gills without damaging the mushroom. For larger species, a light swipe along the gill surface suffices; for smaller ones, a delicate dabbing motion works best. Avoid touching the cap or stem to prevent contamination. Work over a clean, white surface to catch the spores, which are often microscopic and require contrast for visibility. Practice on a few mushrooms first to refine your technique before attempting large-scale collection.
Storage is as crucial as collection. Transfer spores immediately into a paper envelope labeled with the species name, location, and date. Paper envelopes are ideal because they allow moisture to escape, preventing mold growth. Avoid plastic bags, which trap humidity and degrade spore quality. Store envelopes in a cool, dry place, away from direct sunlight. For long-term preservation, consider freezing spores in airtight glass vials, though this method requires more specialized equipment.
Wild harvesting is both an art and a science, demanding respect for the environment. Always collect sustainably—take only a fraction of mushrooms in any given area to allow spore dispersal and ecosystem balance. Be mindful of local regulations, as some regions restrict foraging in protected areas. By combining careful observation, precise technique, and ethical practices, you can gather spores that are not only viable but also responsibly sourced, ensuring a successful and sustainable harvest.
End Food Hoarding in Spore: Effective Strategies to Encourage Sharing
You may want to see also

Spore Prints: Place mushroom cap gills-down on paper, cover, let spores drop, scrape and store
Spores are the microscopic seeds of fungi, and capturing them is a delicate yet rewarding process. One of the simplest and most effective methods is creating spore prints, a technique that leverages the natural dispersal mechanism of mushrooms. By placing a mature mushroom cap gills-down on a piece of paper, you allow the spores to fall naturally, creating a pattern that can be collected and stored for future use. This method is not only accessible but also preserves the genetic material of the mushroom, making it ideal for identification, cultivation, or artistic purposes.
To begin, select a fully mature mushroom with well-developed gills. Gently twist the cap off the stem to avoid damaging the delicate structures. Place the cap gills-down on a piece of clean, white paper or glass for contrast. Cover the setup with a bowl or jar to create a humid environment that encourages spore release. Leave it undisturbed for 6–24 hours, depending on the species and humidity levels. The spores will drop onto the surface, forming a distinct pattern that reflects the mushroom’s gill arrangement. For darker spores, use a clear glass or transparent film to observe the print without disturbing it.
Once the spores have fallen, carefully lift the cap to avoid smudging the print. If the spores are light-colored, gently scrape them from the paper using a sterile scalpel or spatula into a small, airtight container. For darker spores, a piece of the paper itself can be stored. Label the container with the mushroom species, date, and location of collection. Store in a cool, dark place to maintain viability. Properly collected spores can remain viable for years, though freshness is key for successful germination in cultivation projects.
While spore printing is straightforward, there are pitfalls to avoid. Ensure the mushroom is free of dirt or debris, as contaminants can ruin the print or affect cultivation. Humidity is critical; too dry an environment slows spore release, while excessive moisture can cause mold. Always work with sterile tools to prevent contamination. For educational or artistic purposes, spore prints can be framed or pressed between glass for display, showcasing the unique beauty of fungal reproduction. This method bridges science and art, offering both practical and aesthetic value.
How Long Do Spore Syringes Stay Good: A Comprehensive Guide
You may want to see also

Online Vendors: Purchase spore syringes or prints from reputable suppliers, ensure legality in your region
Purchasing spore syringes or prints online is a straightforward way to acquire high-quality spores for microscopy or cultivation, but it requires careful consideration. Start by identifying reputable vendors known for their transparency, customer reviews, and adherence to legal standards. Look for suppliers who provide detailed product descriptions, including spore strain information and storage recommendations. A reliable vendor will often offer lab-grade syringes or prints, ensuring purity and viability for your intended use.
Legality is paramount when buying spores online. While many regions permit the purchase of spores for microscopy or educational purposes, laws vary widely. Research your local regulations to avoid unintentional violations. Reputable vendors typically operate within legal boundaries, offering products labeled "for microscopy use only" to comply with restrictions. Always verify the vendor’s shipping policies and ensure they align with your region’s laws before placing an order.
When selecting a spore product, consider your specific needs. Syringes are ideal for injecting spores directly into substrate, while prints offer a more hands-on approach for slide preparation or inoculation. Dosage isn’t a concern here, as spores are not consumed, but proper handling is crucial. Use sterile tools and work in a clean environment to prevent contamination. Practical tips include storing spores in a cool, dark place and using them within six months for optimal results.
Comparing vendors can save you time and money. Look for suppliers offering competitive pricing without compromising quality. Some vendors provide bulk discounts or loyalty programs, which can be beneficial for frequent buyers. Additionally, check for customer support availability—a responsive team can address concerns and guide you through the purchasing process. By prioritizing reputation, legality, and product suitability, you’ll ensure a smooth and compliant spore acquisition experience.
Can Spraying Lysol Trigger Mold Growth? Uncovering the Truth
You may want to see also

Sterile Lab Techniques: Use agar plates, sterile tools, and pressure cookers to isolate and cultivate spores
Spores, the resilient survival structures of fungi and certain bacteria, require meticulous handling to isolate and cultivate successfully. Sterile lab techniques are paramount to prevent contamination, ensuring the purity of your spore cultures. This process hinges on three critical tools: agar plates, sterile instruments, and pressure cookers.
Agar plates, solidified growth media, provide a nutrient-rich environment for spore germination. Their jelly-like consistency allows spores to adhere and develop into visible colonies. Autoclaving, achieved through a pressure cooker, is the gold standard for sterilization. This process uses steam under pressure (121°C, 15 psi for 15-20 minutes) to eliminate all microorganisms, including spore-forming bacteria.
The process begins with preparing your agar plates. Select a suitable agar recipe based on the organism you're targeting. Common choices include Potato Dextrose Agar for fungi and Nutrient Agar for bacteria. Sterilize the agar solution in the pressure cooker, then carefully pour it into sterile Petri dishes within a laminar flow hood, a cabinet providing a sterile airflow. Allow the agar to solidify completely before use.
Next, obtain your spore sample. This could be from a spore print, environmental swab, or existing culture. Using sterile technique, transfer a small portion of the sample onto the agar plate's surface. This is where sterile tools like inoculation loops and needles become essential. Flame-sterilize these instruments before and after each use to prevent cross-contamination.
Incubate the inoculated plates at the optimal temperature for your target organism. Fungi typically thrive between 25-30°C, while bacteria may require 37°C. Regularly inspect the plates for colony growth. Isolated colonies represent individual spores that have germinated. These can be further subcultured onto fresh agar plates for purification and expansion of your spore culture. Remember, maintaining sterility throughout the process is crucial. Work in a clean environment, minimize exposure to air, and handle all materials with sterile technique to ensure the success of your spore isolation and cultivation efforts.
Are Spores Male or Female? Unraveling the Mystery of Fungal Reproduction
You may want to see also

Spore Swabs: Swab mushroom gills with a sterile cotton swab, transfer spores to a storage medium
A sterile cotton swab is your precision tool for capturing mushroom spores directly from the gills, where they naturally disperse. This method, known as spore swabbing, is ideal for species with delicate or hard-to-access gills, ensuring minimal disturbance to the fruiting body. Begin by selecting a mature mushroom with fully developed gills, as younger specimens may not have released spores yet. Gently press the swab against the gills, using a light, rolling motion to collect the microscopic spores without damaging the structure.
The success of spore swabbing hinges on sterility. Use an alcohol-sterilized swab or flame-sterilize it with a lighter before and after collection to prevent contamination. Once collected, transfer the spores to a storage medium like agar, water, or a specialized spore vial. For agar, streak the swab in a zigzag pattern across the surface; for liquid mediums, gently swirl the swab to release spores. Label the storage container with the mushroom species, date, and location for future reference.
Comparatively, spore swabbing offers advantages over spore prints, especially for mushrooms with fragile caps or those growing in clusters. While spore prints require a clean, dry surface and time for spores to drop, swabbing is immediate and controlled. However, swabbing collects fewer spores, making it less ideal for large-scale cultivation but perfect for microscopy, research, or small-batch inoculations.
Practical tips: Store spore swabs in a cool, dark place to maintain viability. For long-term storage, refrigerate at 2–4°C (36–39°F) or freeze at -20°C (-4°F). Avoid touching the swab tip with your hands or unsterilized surfaces. If using a microscope, rehydrate a small portion of the swab’s spores in a drop of water on a slide for clear observation. Master this technique, and you’ll unlock a reliable, precise way to collect and preserve mushroom spores for any purpose.
Are Shrooms Spores Legal? Exploring the Legal Landscape of Psilocybin
You may want to see also
Frequently asked questions
The most common methods include purchasing spore syringes or prints from reputable vendors, collecting spores from mature mushrooms in the wild using a spore print technique, or joining spore trading communities.
In most regions, collecting spores is legal since they are not considered a controlled substance. However, always check local laws and ensure you are not trespassing on private property or protected areas.
Place a mature mushroom cap gills-down on a piece of foil or glass for 24 hours. The spores will drop and create a visible print, which can then be stored or used for cultivation.
Spore syringes are more convenient and ready-to-use for inoculation, while spore prints require additional steps to prepare. Both are effective, so choose based on your preference and experience level.
Purchase spores from reputable online vendors that specialize in mushroom cultivation supplies. Ensure they comply with local laws and provide high-quality, viable spores for your needs.